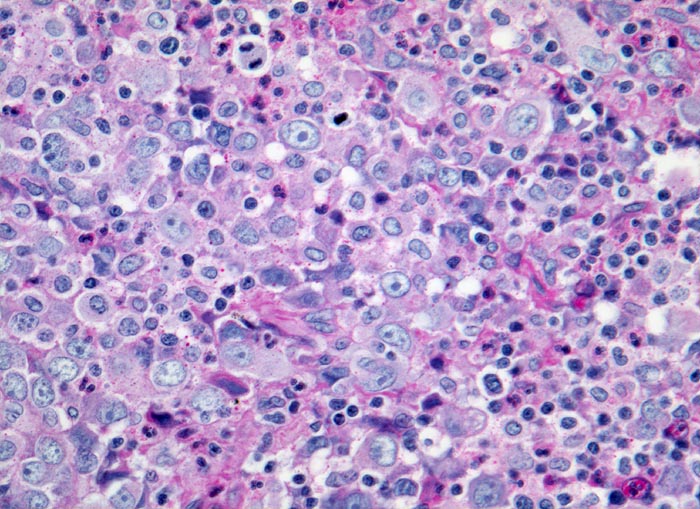

PathoPic – image database / PathoPic ID 3767 - Nasopharynxkarzinom: Lymphknotenmetastase
de
Diagnose
Nasopharynxkarzinom: Lymphknotenmetastase
Diagnose Gruppe
maligner Tumor
Topographie
Lymphknoten, Kopf-cervikal
Topographie Gruppe
Lymphatische Gewebe, KM, Milz
Beschreibung
Diskohäsives Infiltrat eines grosszelligen Tumors. Die Tumorzellen besitzen grosse helle runde oder ovale Kerne mit einem oder mehreren prominenten Nukleolen (Fehldiagnose Hodgkin Lymphom!). Zwischen den Tumorzellen Lymphozyten und Granulozyten.
Klinik
Seit 6 Monaten zunehmende Halsschwellung rechts
Kommentar
Häufige Verwechslung mit Hodgkin- oder Non Hodgkin Lymphomen, da die Lymphknotenmetastasen oftmals Erstmanifestation eines sehr kleinen nasopharyngealen Karzinoms im Nasopharynxbereich sind.
Bilder Typ
Histologie
Vergrösserung
320
Alter
62
Geschlecht
männlich
Datum
Ersteintrag: 31.12.2001